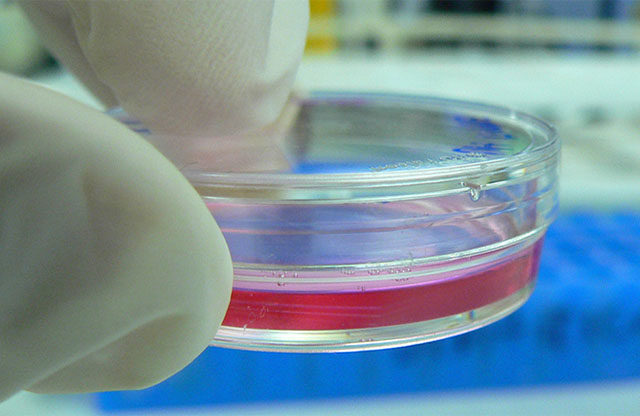
Cultivar órganos para transplantes

Un fármaco contra el cáncer de pulmón (denominado pembrolizumab), recientemente aprobado por la Comisión Europea, es mucho más eficaz y menos tóxico que los tratamientos habituales de quimioterapia. Además, es ideal para aumentar la supervivencia de los pacientes, con cierta…
Noticias
Por qué los trastornos del espectro autista son más numerosos en varones
Los trastornos del espectro autista (TEA) afectan a uno de cada 100 nacimientos y suelen ser mucho más comunes en varones. De hecho, por cada niña diagnosticada de un TEA hay cuatro niños afectos. Esto es lo que ha llevado…
La formación de las conexiones neuronales en los niños
La ciencia lleva años advirtiendo de la importancia de la primera infancia en la formación de las conexiones neuronales en los niños. Durante los primeros tres años de vida de los menores es cuando se crea toda la arquitectura cerebral,…
Enfermedades psicosomáticas que provocan síntomas muy reales
La neuróloga irlandesa Suzanne O’Sullivan está especializada en enfermedades psicosomáticas. Tras más de 20 años de carrera lidiando con pacientes que padecen síntomas extremadamente reales para enfermedades que, físicamente, no existen, esta doctora ha decidido publicar un libro al respecto.…
El sedentarismo provoca envejecimiento celular prematuro
Las sociedades médicas y científicas recomiendan practicar deporte cada día y evitar, así, el sedentarismo constante. Con treinta minutos de ejercicio diario debería de ser suficiente para notar los grandes beneficios que esto aporta en el organismo. Ahora, un estudio…
Cultivar órganos para trasplantes: cada vez más cerca
Un estudio reciente, llevado a cabo por investigadores del Instituto de Ciencias Médicas de la Universidad de Tokio, en colaboración con la Facultad de Medicina de la Universidad de Stanford, ha logrado ofrecer un nuevo enfoque en la medicina regenerativa.…
El déficit de vitamina A durante el embarazo podría desencadenar el Alzhéimer
Numerosos estudios han demostrado que la enfermedad de Alzhéimer puede estar relacionada con diferentes factores genéticos y ambientales. Entre ellos, la deficiencia de algunas vitaminas puede ser clave. Esto es lo que se demuestra en una investigación llevada a cabo…
Estados Unidos aprueba el fármaco contra la Atrofia Muscular Espinal
A veces la ciencia da sorpresas que se convierten en grandes hallazgos para tratar enfermedades potencialmente mortales. El investigador uruguayo Adrian Krainer trabajaba hace años para conocer la forma en que la naturaleza genética actuaba y cómo se expresan los…
Nuevo tratamiento para el trastorno límite de personalidad
Los fármacos poco pueden hacer para tratar a personas que sufren trastorno límite de personalidad. Actualmente, existe un novedoso tratamiento, llamado terapia dialéctica conductual, que está logrando eficaces resultados en Estados Unidos y Europa, donde más se recurre a él.…